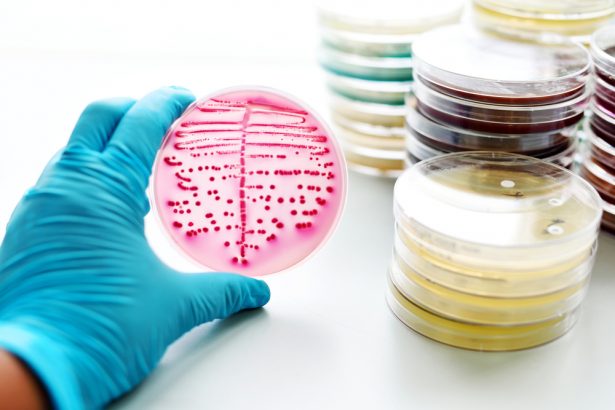

La ‘chaude-pisse’ de plus en plus difficile à combattre, selon l’OMS
L’Organisation mondiale de la santé (OMS) nous apprend dans un communiqué que la gonorrhée (chaude-pisse) serait de plus en plus difficile à soigner, car elle résiste aux antibiotiques.

La gonorrhée, également appelée chaude-pisse, est le parasite de l’une des principales infections sexuellement transmissibles (IST). Selon le rapport de l’OMS publié le 7 juillet 2017, plus de 78 millions de personnes en seraient atteintes chaque année. Problème : la bactérie évolue et résiste désormais mieux aux différents traitements. L’OMS s’inquiète de l’augmentation des cas de gonorrhées résistantes aux antibiotiques.
78 millions de personnes atteintes de gonorrhée ou chaude-pisse chaque année
La gonorrhée, que l’on nomme aussi la blennorragie, affecte notamment les organes génitaux, la gorge et le rectum. La transmission se fait lors de rapports non protégés par voie orale, anale ou vaginale. Si elle n’est pas traitée, la maladie peut entraîner des douleurs pelviennes et des cystites chroniques chez les femmes, des douleurs testiculaires chez les hommes, ainsi que l’infertilité dans certains cas.
Selon les estimations de l’OMS, 78 millions cas de gonorrhée sont enregistrés chaque année. En effet, le rapport montre que l’infection se développe principalement dans les pays les plus pauvres, moins aptes à surveiller les niveaux de résistance. Pourtant, la maladie est aussi très présente en Espagne, au Japon et en France où elle a augmenté de 100 % chez les hommes homo ou bisexuels, de 32 % chez les femmes hétérosexuelles et de 8 % chez les hommes hétérosexuels entre 2013 et 2015, précise l’Institut national de veille sanitaire.
Une résistance aux antibiotiques qui inquiète l’OMS
S’il existe des traitements pour soigner la gonorrhée, cela semble ne plus suffire. En effet, la bactérie responsable évolue et devient plus résistante aux antibiotiques, s’alarme l’OMS. De plus, il n’existe aujourd’hui aucun test rapide pour diagnostiquer la gonorrhée. Ainsi, les médecins traitent ces infections « à l’aveugle« , ce qui génère souvent des traitements inadaptés, favorisant l’émergence de souches résistantes.
Actuellement, seuls trois nouveaux médicaments pour traiter la chaude-pisse sont à l’étude. Selon plusieurs spécialistes, à plus long terme, un vaccin doit être envisagé pour prévenir cette IST. L’OMS et l’Initiative Médicaments contre les maladies négligées (DNDi) ont lancé le Partenariat mondial sur la recherche-développement en matière d’antibiotique pour mettre au point de nouveaux traitements.
Pour le moment, le meilleur moyen de se protéger contre la chaude-pisse reste l’usage correct et régulier du préservatif.
Illustration bannière : FLa chaude-pisse vue au microscope- © fotovapl
A lire absolument

Tiens !! une nouvelle promotion pour un futur vaccin :):)
Vivement un vaccin contre la bêtise !
Aucun vaccin n’est possible car les bactérie se loge à un endroit ou le système immunitaire n’agit pas. Mais il y a des plantes médicinale qui son éfficase (la bruyère, le buis, le gyrofle, la myrtille). Essayer l’huile éssentièle de menthe aquatique qui est un puissant antibiotique.